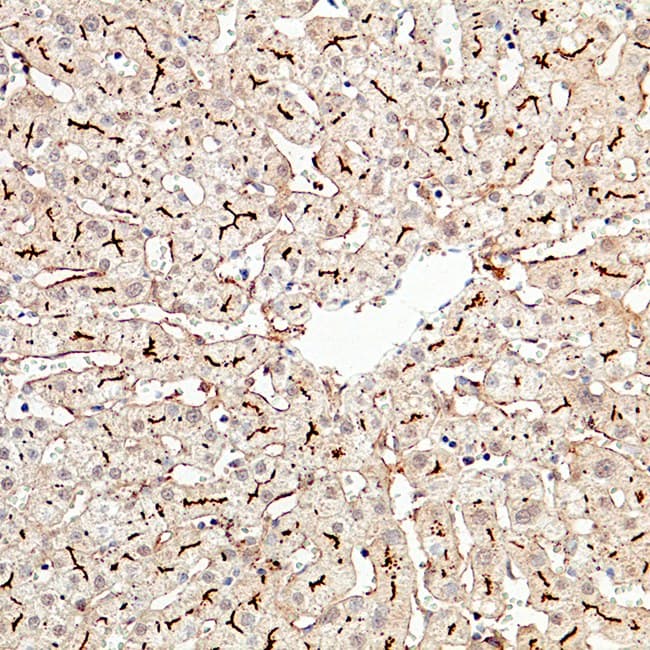

El Cluster of differentiation 10 (CD10), también conocido como antígeno común de leucemia linfoblástica aguda (CALLA), es una metaloendopeptidasa neutra de superficie celular (neprilisina) con actividad enzimática que modula la señalización peptídica. Bioquímicamente, CD10 escinde e inactiva una variedad de péptidos pequeños, lo que influye en los microambientes celulares y las vías de transducción de señales. Fisiológicamente, CD10 se expresa en progenitores linfoides tempranos y células B del centro germinal, reflejando su papel en el desarrollo y diferenciación linfoide. CD10 también está presente en tejidos no hematopoyéticos seleccionados (p. ej., epitelio renal) debido a sus funciones enzimáticas más amplias.
Significado biológico de CD10
- Marcador de desarrollo: CD10 identifica etapas tempranas de la línea celular B y células B del centro germinal, reflejando puntos clave de diferenciación en la linfopoyesis.
- Rol funcional: Como metaloendopeptidasa, CD10 regula los niveles de péptidos extracelulares, lo que afecta la comunicación intercelular y puede influir en el comportamiento neoplásico.
Utilidad diagnóstica en hematopatología
- Clasificación de neoplasias linfoides: CD10 se utiliza ampliamente en paneles de inmunohistoquímica (IHC) para distinguir malignidades de linaje B — especialmente linfoma folicular, leucemia linfoblástica aguda B (B-ALL), linfoma de Burkitt y subtipos de linfoma difuso de células B grandes — debido a su expresión variable en estas entidades.
- Perspectivas pronósticas y diferenciales: En linfomas foliculares, la positividad para CD10 apoya un fenotipo de centro germinal; en DLBCL, su presencia ayuda en la subclasificación y puede correlacionarse con los resultados clínicos.
- Marcador complementario: Aunque altamente específico para la expresión en centro germinal y células B tempranas, el rendimiento de la IHC de CD10 debe integrarse en paneles más amplios y en el contexto morfológico debido a la sensibilidad variable en comparación con la citometría de flujo.
Características clave de los anticuerpos CD10 CE/IVD para IHC
- Reactivos validados CE/IVD: Los anticuerpos anti-CD10 diseñados para uso IVD están cualificados para la detección inmunohistoquímica de CD10 en tejidos humanos fijados en formalina e incluidos en parafina (FFPE) e destinados a la interpretación clínica por patólogos cualificados.
- Especificidad monoclonal: Los anticuerpos monoclonales de conejo o ratón (p. ej., clones SP67, 56C6) exhiben alta especificidad para el antígeno CD10, minimizando la reactividad cruzada y produciendo tinción membranosa y/o citoplasmática en células positivas.
- Rendimiento IHC optimizado: Estos anticuerpos son compatibles con plataformas automatizadas y tinción manual, requiriendo recuperación antigénica y controles apropiados para una detección precisa en paneles de hematopatología.
- Paneles diagnósticos: La IHC de CD10 se incorpora rutinariamente en paneles de IHC para linfomas y leucemias junto con marcadores como BCL-6, CD20 y CD3 para refinar el linaje y el estado de diferenciación.